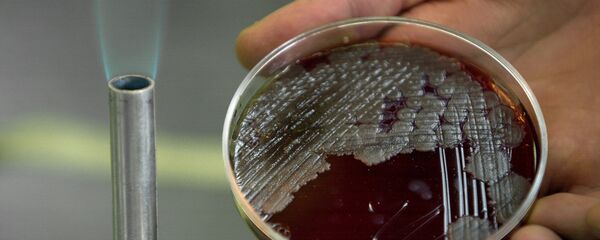
آنتی بیوتیک - اسپوتنیک ایران

به گزارش اسپوتنیک، مطابق با دادههای دانشگاه جانز هاپکینز، بیش از 4 میلیون و 500 هزار نفر در دنیا به کروناویروس مبتلا شدهاند که از این تعداد بیش از 300 هزار نفر درگذشتند. به عقیده دانشمندان زئونوزها (زئونوزها گروهی از بیماریهای عفونی هستند که بطور طبیعی بین حیوانات مهره دار و انسانها قابل انتقال هستند) عامل حدود 70 درصد ظهور بیماریهای عفونی در بین مردم هستند.
افزون برآن، حدود 1 میلیون و 700 هزار ویروس دیگر در طبیعت می تواند وجود داشته باشد که برای دانشمندان ناشناخته است. به گفته متخصص ویروس شناس پیتر داسزاک از EcoHealth Alliance، سه عامل می تواند باعث بروز اپیدمیهای بعدی شود: نقاط مسکونی پرجمعیت، تنوع گیاهی و حیوانی و تغییر سریع وضعیت اکولوژیکی.
بیشترین ویروس هایی که انسان با آن روبرو شده است از حیوانات به انسان منتقل شدهاند. به عنوان مثال، ویروس « گریپ آ»، در پرندگان دریایی وحشی شکل گرفت و بعد از آنها به حیوانات خانگی و انسان منتقل شد و موش ها باعث شیوع تب «لاسا» در بین ساکنان آفریقای غربی شدند. اما مسأله نه با جانوران، بلکه با انسان ارتباط دارد. زیرا انسان به تصرف طبیعت می پردازد. تجمع زیاد افراد در یک محل می تواند باعث بروز اپیدمی های بعدی شود.
افزون بر آن آب شدن یخچالها نیز می تواند سهم خطرناکی در این روند ایفا کنند. آب شدن یخ ها باعث آزاد شدن میکروب ها و ویروس هایی می شود که طی دهها و صدهاهزار سال در میان یخها گرفتار بودند.
در سال 2016 میلادی یک تراژی واقعی رخ داد و پس از آب شدن یخ ها، برای اولین بار طی 75 سال در سالخارد، شیوع سیاهزخم یا آنتراکس (بیماری باکتریایی) بروز کرد. دلیل آن اپیدمی میکروارگانیزمهایی بود که در گورهای یخی دفن شده بردند. می توان تصور کرد که چه مقدار ویروس دیگر در یخجالها در خواب هستند. در ماه مارس سال 2019، در قطب شمال ویروسی کشف شد که عمر آن بیش از 30 هزار سال ارزیابی شده است.